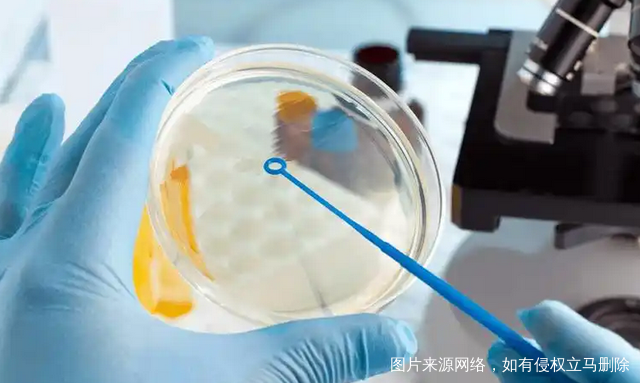
29

人工授精与试管婴儿属于两种广泛采用的人工辅助生殖技术,专为那些因种种原因难以自然受孕的夫妇设计,旨在圆满他们的生育梦想。面对这两种选择,许多夫妇可能会感到困惑,不知道哪种方法更适合自己。本文将详细解析人工授精与试管婴儿的区别、各自的优缺点以及选择依据,以帮助夫妇们做出明智的决策。
一、人工授精与试管婴儿的区别
1. 助孕方式:人工授精是通过采集男性的精液,经过处理后直接放入女性生殖道内,以促进受孕。而试管婴儿则是将精子与卵子分别取出体外,在实验室条件下完成受精过程,再将受精卵培养成胚胎后移植回母体子宫内。
2. 受精位置:人工授精的受精位置在女性生殖道内,而试管婴儿的受精过程则在体外进行。
3. 治疗周期:人工授精的治疗周期相对较短,通常只需一个月左右。而试管婴儿的治疗周期较长,可能需要2-3个月的时间。
4. 适用范围:人工授精主要适用于男性轻度精子质量异常、女性宫颈性不孕等情况。试管婴儿则适用于多种原因导致的不孕问题,如男性精子严重异常、女性输卵管梗阻、子宫内膜异位症等。
5. 胚胎选择:人工授精并不需要进行胚胎选择,而试管婴儿则可能需要进行胚胎筛选,以确保移植的胚胎健康正常。
二、人工授精的优缺点
优点:
1. 简单便捷:人工授精操作相对简单,对女性的身体伤害较小。
2. 周期短:治疗周期短,不会过多浪费患者的时间和精力。
3. 费用少:相较于试管婴儿,人工授精的费用更为经济。
缺点:
1. 成功率不高:人工授精的成功率较低,约为15%左右,受到女性身体因素和不孕因素的影响。
2. 感染风险:手术过程中如果不注意消毒,可能导致子宫和输卵管感染。
3. 出血和损伤:操作失误可能造成宫颈管和子宫内膜损伤出血。
三、试管婴儿的优缺点
优点:
1. 解决不孕不育问题:试管婴儿技术能够解决多种原因导致的长期不孕不育问题。
2. 胚胎筛选:通过胚胎筛选技术,可以确保移植的胚胎健康正常,降低遗传性疾病的风险。
缺点:
1. 费用高昂:试管婴儿的治疗费用较高,包括促排卵、取卵、移植以及后续胚胎的解冻、冷冻等费用。
2. 并发症风险:试管婴儿过程中可能出现卵巢过度刺激综合征、穿刺后的出血、感染等并发症。
3. 流产和早产风险:试管婴儿流产和早产的风险略高于自然妊娠,尤其是高龄产妇和多胎妊娠的情况。
四、如何选择
在选择人工授精或试管婴儿时,夫妇们应综合考虑以下因素:
1. 病情因素:根据夫妇双方的具体不孕原因,选择最适合的助孕方式。
2. 年龄因素:随着年龄的增长,女性的生育能力逐渐下降。对于高龄夫妇,试管婴儿可能更为合适。
3. 生育需求:如果夫妇希望尽快实现生育愿望,且经济条件允许,试管婴儿可能是一个更好的选择。
4. 经济情况:试管婴儿的费用远高于人工授精,因此经济因素也是选择时需要考虑的重要方面。
以上就是“做人工授精好还是做试管好?到底应该怎么选择?”相关介绍。在选择时,夫妇们应根据自己的具体情况,在专业医生的指导下做出明智的决策。无论选择哪种方式,都应保持积极的心态和良好的生活习惯,以提高受孕成功率。













